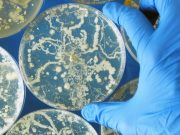
Fewer Cases of Fungal Diseases Coincided With Start of COVID-19

Generalized Joint Hypermobility May Increase Risk for Long COVID
Hypermobility also predicts greater fatigue levels
Four in 10 Adults Choose Telemedicine Visits
Video visits less likely among older patients and those without internet access
Physicians Concerned About Private Equity’s Impact on Health Care
Greatest concerns are around physician well-being, health care spending, and equity
Life Expectancy Increased From 2021 to Reach 77.5 Years in 2022
Second study shows age-adjusted rate of drug overdose deaths increased from 2002 to 2022, but did not change from 2021 to 2022
Fewer Cases of Fungal Diseases Coincided With Start of COVID-19
Fewer cases of each disease occurred in spring versus other seasons in 2020, and most cases occurred in the fall
Study Addresses Nasal Rinsing and Nonkeratitis Acanthamoeba Infection
All 10 patients studied were immunocompromised, seven had chronic sinusitis, and at least four reported using tap water for rinsing
GLP-1 RA Reduces Severity of Steatotic Liver Disease in People With HIV
Semaglutide linked to declines in intrahepatic triglycerides for people with HIV with metabolic-associated steatotic liver disease
Measles Outbreaks Have CDC Tweaking Travel Guidelines
Chicago Migrant Shelter Reports Measles Outbreak
Two adults in stable condition, one school-aged child in good condition, one very young child no longer infectious
Long-Acting Injectable ART Superior to Standard Care for Poorly Adherent People With HIV
Key secondary end points of virologic failure and treatment-related failure met predefined stopping criterion